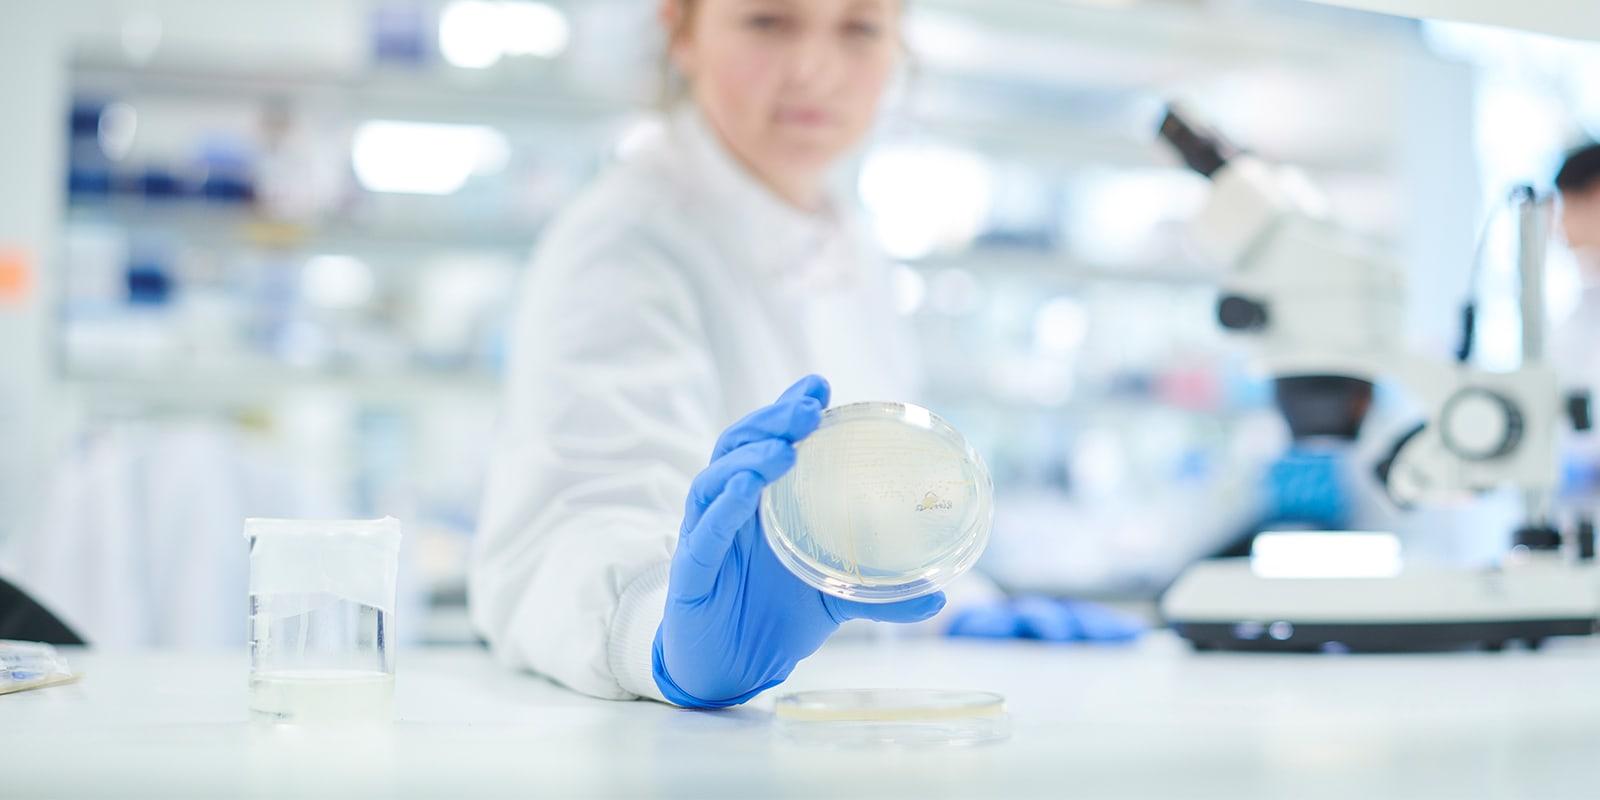

Laboratories
Our Tested Lab Team Can Help You Comply and Compete
Clinical laboratories face unique business challenges. Scientific advances in laboratory testing are evolving at a rapid pace — but so are the legal, regulatory, and reimbursement hurdles facing the industry. We've spent decades representing clinical laboratories. Our daily focus on the industry affords us an in-depth understanding of the key business and legal considerations. We leverage that insight to provide practical, cost-effective advice. Our team can help you maintain a competitive edge while avoiding government scrutiny.
Share AwardsOur Experience
 Case Study
Case Study
 Case Study
Case Study
Our Approach
Our team counsels independent and hospital-based laboratories on all aspects of their business operations. We regularly advise laboratories on legal and regulatory matters spanning the full scope of industry challenges. We advise them on compliance with the Clinical Laboratory Improvement Amendments of 1988 (CLIA) and the implementing regulations as well as state licensure and accreditation requirements. We represent them in litigation and government investigations as well as transactional matters. And we provide advice and counsel on reimbursement issues.
Mintz has earned a national reputation for representing laboratories in significant government investigations and False Claims Act litigation. We have successfully resolved claims related to sales and marketing practices, billing and medical necessity, quality of testing / test kits, and compliance with NIH grant requirements.
- Defense in state and federal administrative actions, investigations, audits, and litigation — including cases brought by whistleblowers under the federal False Claims Act (FCA) and audits conducted by various Medicare contractors
- Representation in agency adverse actions concerning CLIA and state licensure survey deficiencies and Medicare enrollment issues
- Compliance program development / implementation — including employee training in connection with corporate integrity agreements (CIAs)
- Negotiation of CIAs and other settlements with the Office of Inspector General (OIG) for the Department of Health and Human Services
- Review of sales and marketing practices and compliance advice regarding the federal Anti-Kickback Statute, the Stark Law, the FCA, and analogous state laws
- Preparation and submission of self-disclosures to the OIG and Centers for Medicare & Medicaid Services
- Counsel on Medicare reimbursement issues, the prohibition on reassignment, and the lab-to-lab billing requirements
- Advice on compliance with HIPAA, applicable state and federal privacy laws, and data breach laws
- Counsel on compliance with CLIA and state licensure requirements — including test ordering and reporting
- Advice on transaction structuring to comply with corporate practice of medicine restrictions and other federal and state laws
- Representation in transactions and performance of regulatory due diligence
- Oversight of compliance related to change of ownership requirements
- Investors in independent laboratories
- National, full-service, independent laboratories
- Specialty or esoteric laboratories
- Pathology laboratories
- Hospital-based laboratories
Meet Mintz
Our attorneys use their understanding of the industry's key business and legal considerations to provide practical, cost-effective advice and representation.
Our Insights
Viewpoints

FDA’s Backup LDT Enforcement Method: Specimen Collection Kits
March 13, 2025| Blog

Five Observations from FDA’s Responses to Comments in the Final Rule on LDTs
July 10, 2024| Blog
News & Press
Related Practices
- Health Care Compliance, Fraud & Abuse, and Regulatory Counseling
- FDA Regulatory
- Health Information Privacy & Security
- Health Care Transactional Due Diligence
- Health Care Transactions
- Medicare, Medicaid & Commercial Coverage & Reimbursement
- Health Care Enforcement & Investigations
- Private Equity
- Lobbying & Public Policy







